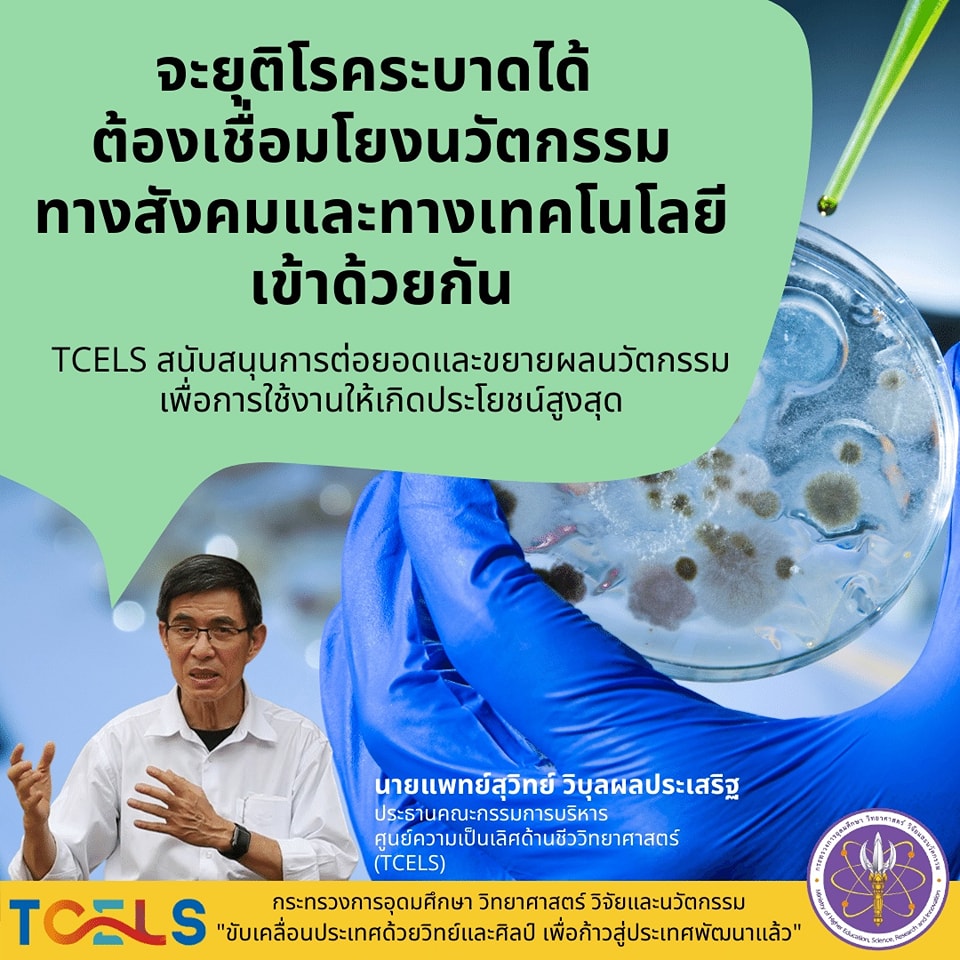
305631830 474040471432278 4825450570093347054 n

การป้องกันและควบคุมโ ...

อว. ร่วมกับสาธารณสุขจังหวัดเชียงใหม่ เดินหน้าปฏิรูประบบสาธารณสุข ให้เป็นต้นแบบการขยายผลนวัตกรรมดิจิทัล
สนับสนุนการบริหารจัดการโรคระบาดในพื้นที่ภาคเหนือ ภายใต้โปรแกรมยุติโรคระบาดด้วยนวัตกรรม (EPI)
มีเป้าหมายให้จังหวัดเชียงใหม่เป็นต้นแบบเมืองมั่นคงด้านสุขภาพ ด้วยการนำนวัตกรรมมาช่วยบูรณาการข้อมูลสุขภาพจากทุกภาคส่วนที่เกี่ยวข้อง
เผยแพร่โดย : นางสาวสุวดี เหมือนอ้น
กลุ่มสื่อสารองค์กร (สอ.)
กระทรวงการอุดมศึกษา วิทยาศาสตร์ วิจัยและนวัตกรรม
โทรศัพท์ 0 2333 3700 ต่อ 3880
E-mail : pr@mhesi.go.th
Facebook : @MHESIThailandth
Instagram : mhesi_thailand
Tiktok : mhesi_thailand
Twitter : @MHESIThailand
Call Center โทร.1313
![]()
- อว.พารับส่วนลด
- User Menu (Discount)
- แนะนำหน่วยงาน
- ภาพข่าวและกิจกรรม
กระทรวงการอุดมศึกษา วิทยาศาสตร์ วิจัยและนวัตกรรม (อว.)
เป็นหน่วยงานของรัฐที่จัดตั้งขึ้นเพื่อขับเคลื่อนการอุดมศึกษาไทย วิทยาศาสตร์ วิจัยและนวัตกรรม ไปสู่มาตรฐานในระดับสากล และเพิ่มอันดับความสามารถการแข่งขันในระดับนานาชาติอย่างยั่งยืน ไม่ได้มีวัตถุประสงค์เพื่อแสวงหากำไร หากท่านพบว่ามีข้อมูลใดๆ ที่ละเมิดทรัพย์สินทางปัญญาปรากฏอยู่ในเว็บไซต์นี้ โปรดแจ้งให้ทราบ เพื่อดำเนินการแก้ปัญหาดังกล่าวโดยเร็วที่สุดต่อไป
© 2020 Ministry of Higher Education, Science, Research and Innovation. ALL RIGHTS RESERVED.




